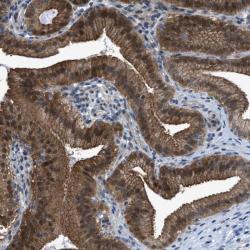

Antibody data
- Antibody Data
- Antigen structure
- References [3]
- Comments [0]
- Validations
- Western blot [1]
- Immunohistochemistry [1]
Submit
Validation data
Reference
Comment
Report error
- Product number
- sc-32282 - Provider product page

- Provider
- Santa Cruz Biotechnology
- Proper citation
- Santa Cruz Biotechnology Cat#sc-32282, RRID:AB_628104
- Product name
- Anti-PARK2
- Antibody type
- Monoclonal
- Reactivity
- Human
- Host
- Mouse
Submitted references PARK2 deletions occur frequently in sporadic colorectal cancer and accelerate adenoma development in Apc mutant mice.
Parkin selectively alters the intrinsic threshold for mitochondrial cytochrome c release.
A regulated interaction with the UIM protein Eps15 implicates parkin in EGF receptor trafficking and PI(3)K–Akt signalling
Poulogiannis G, McIntyre RE, Dimitriadi M, Apps JR, Wilson CH, Ichimura K, Luo F, Cantley LC, Wyllie AH, Adams DJ, Arends MJ
Proceedings of the National Academy of Sciences of the United States of America 2010 Aug 24;107(34):15145-50
Proceedings of the National Academy of Sciences of the United States of America 2010 Aug 24;107(34):15145-50
Parkin selectively alters the intrinsic threshold for mitochondrial cytochrome c release.
Berger AK, Cortese GP, Amodeo KD, Weihofen A, Letai A, LaVoie MJ
Human molecular genetics 2009 Nov 15;18(22):4317-28
Human molecular genetics 2009 Nov 15;18(22):4317-28
A regulated interaction with the UIM protein Eps15 implicates parkin in EGF receptor trafficking and PI(3)K–Akt signalling
Lara Fallon, Catherine M.L. Bélanger, Amadou T. Corera, Maria Kontogiannea, Elsa Regan-Klapisz, France Moreau, Jarno Voortman, Michael Haber, Geneviève Rouleau, Thorhildur Thorarinsdottir, Alexis Brice, Paul M.P. van Bergen en Henegouwen, Edward A. Fon
Nature Cell Biology 2006 Jul;8(8):834-842
Nature Cell Biology 2006 Jul;8(8):834-842
No comments: Submit comment
Supportive validation
- Submitted by
- per
- Main image

- Experimental details
- Western blot analysis of antibody specificity using a routine panel composed of IgG/HSA-depleted human plasma and protein lysates from selected human tissues and cell lines.
- Validation comment
- Single band corresponding to the predicted size in kDa (+/-20%).
- Primary Ab dilution
- 1:500
- Secondary Ab dilution
- 1:7000
- Lane 1
- Marker [kDa]: 250, 130, 95, 72, 55, 36, 28, 17, 11
- Lane 2
- RT-4
- Lane 3
- U-251MG sp
- Lane 4
- Human Plasma
- Lane 5
- Liver
- Lane 6
- Tonsil
- Theoretical target weight
- [kDa] 52
Supportive validation
- Submitted by
- per
- Main image
- Experimental details
- Immunohistochemical staining of human gall bladder shows cytoplasmic and nuclear positivity in glandular cells.
- Validation comment
- Staining pattern partly consistent with experimental and/or bioinformatic data.